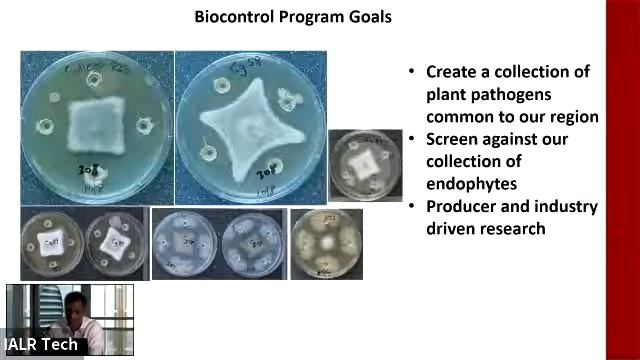
Exploring The Potential Of Beneficial Bacterial Endophytes For Disease Control

Грибы: магия естественной красоты
- ⌚ 03.02.2025 лапша по китайски
- ⌚ 03.02.2025 У нас урок биологии по теме грибы🍄😂
- ⌚ 03.02.2025 Тает железо
- ⌚ 03.02.2025 Собираем грибы в лесу - Position #1
- ⌚ 03.02.2025 -ILSI NA – Microbiome 2017: Microbiome Of Fresh Produce (Andrea Ottesen)
- ⌚ 03.02.2025 Exploring The Potential Of Beneficial Bacterial Endophytes For Disease Control
- ⌚ 03.02.2025 Гречневая лапша с грибами
- ⌚ 03.02.2025 รีวิวงานครับผม
- ⌚ 03.02.2025 TUGAS BIOLOGI ! 🐳 || Cara Membuat Tempe 🌈🌿
- ⌚ 03.02.2025 алфавит лор смотреть
- ⌚ 03.02.2025 Kordiseps Bio əlavə. İnstagram/tiens_official_aze Əlaqə üçün: 099-722-90-99
- ⌚ 03.02.2025 Евгений в прямом . Всем добра
- ⌚ 03.02.2025 Бери грибы
- ⌚ 03.02.2025 Virtual ID Table And Fall Bingo Announcement - Annie Weissman (MAWDC 10/6/22)
- ⌚ 03.02.2025 Moscow: Autumn Honey Mushrooms. Осенние опята.
- ⌚ 03.02.2025 TRICHODERMA SPP COMO AGENTE DE CONTROL BIOLOGICO
- ⌚ 03.02.2025 ИСТОРИЯ ГРИБА 3 ЧАСТЬ//SENOPICK
- ⌚ 03.02.2025 Ляльковий театр "АТМОСФЕРА РАДОСТІ" Зібранівська ЗОШ
- ⌚ 03.02.2025 [Меме]~Не трожь её!
- ⌚ 03.02.2025 Собираем много грибов! Подосиновики / Латвия, г.Вентспилс / 02.10.2023

![[Меме]~Не трожь её!](http://pic.rtbcdn.ru/video/2025-02-03/81/6f/816f17b9725d797a471228e5538fcdc2.jpg)
